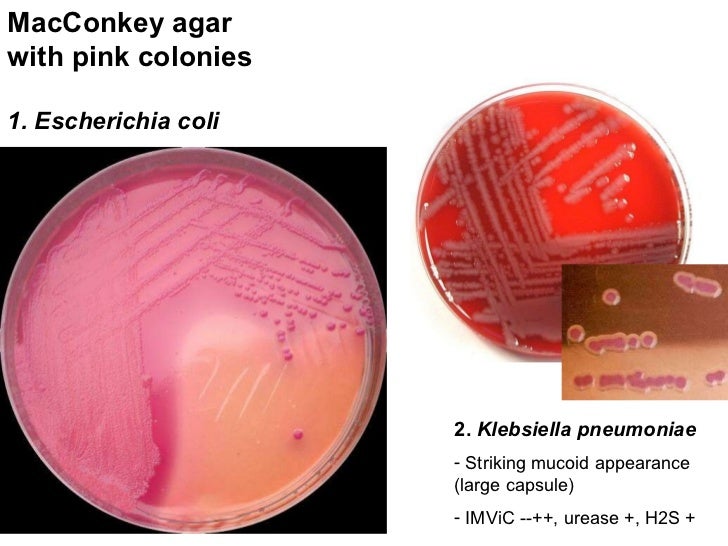

Фотографии, показывающие токсигенность Клебсиеллы

:quality(85)/cloudfront-us-east-1.images.arcpublishing.com/infobae/SLFC2IR4E5FQXP3RLXN3RXFXQU.jpg)











































































































Раздел: Другие животные